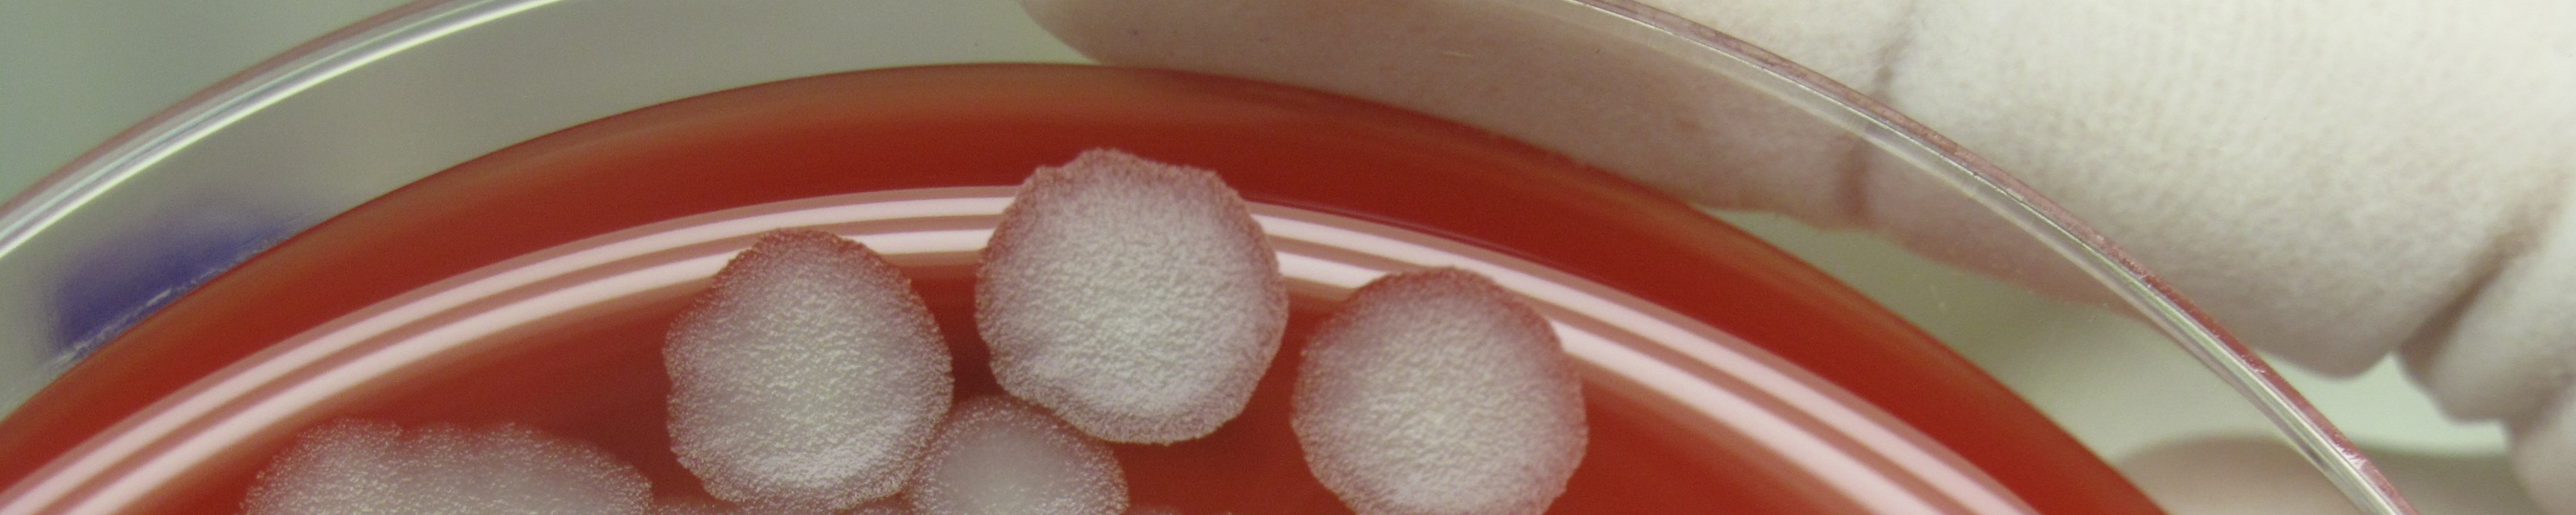

Nombre: Nerea García Benzaquén
Localization: Centro de Vigilancia Sanitaria Veterinaria (VISAVET) U.C.M., Madrid, España
ACTUALMENTE Y TRAS OBTENER MI DOCTORADO EN VETERINARIA EN EL AÑO 2009 SOY LA RESPONSABLE DEL SERVICIO DE ZOONOSIS EMERGENTES, DE BAJA PREVALENCIA Y AGRESIVOS BIOLOGICOS DEL CENTRO DE VIGILANCIA SANITARIA VETERINARIA (VISAVET) DE LA UCM, AL QUE SME INCORPORE EN EL AÑO 2001, Y QUE SE ENCARGA PRINCIPALMENTE DE REALIZAR TAREAS DE VIGILANCIA EPIDEMIOLOGICA Y MONITORIZACION DE PATOGENOS EMERGENTES Y/O IGNORADOS EN DISTINTAS ESPECIES HOSPEDADORES Y VECTORES. EN MI HABER CUENTO CON AMPLIA EXPERIENCIA EN LABORATORIO (PRINCIPALMENTE DIAGNOSTICO Y CARACTERIZACION MICROBIOLOGICA), TRABAJO EN EL NIVEL DE BIOSEGURIDAD 3, EXPERIENCIA DE CAMPO CON DISTINTAS ESPECIES ANIMALES, DESARROLLO DE PROGRAMAS DE VIGILANCIA EPIDEMIOLOGICA, ELABORACION DE INFORMES, ETC. HE PARTICIPADO EN MULTITUD DE PROYECTOS DE INVESTIGACION (13) Y EN CONTRATOS Y CONVENIOS CON EMPRESAS Y ADMINISTRACIONES (50). LA ACTIVIDAD INVESTIGADORA SE HA REFLEJADO EN LA PARTICIPACION EN 14 ARTICULOS CIENTIFICOS INTERNACIONALES Y 9 NACIONALES, 24 COMUNICACIONES EN POSTER Y 10 ORALES EN CONGRESOS NACIONALES E INTERNACIONALES. ADEMAS, HE SIDO BENEFICIARIA DE DOS BECAS PARA REALIZAR ESTANCIAS EN EL EXTRANJERO: PREDOCTORAL EN FACULTAD DE VETERINARIA Y ZOOTECNIA DE LA UNIVERSIDAD AUTONOMA DE MEJICO Y POSDOCTORAL (PROGRAMA JOSE CASTILLEJO DEL MINISTERIO DE EDUCACION) EN EL CENTRO PARA EL CONTROL Y PREVENCION DE ENFERMEDADES (CDC) DE ATLANTA (USA). POR OTRA PARTE, HE AMPLIADO MI FORMACION ACADEMICA ASISTIENDO A DIVERSOS CONGRESOS Y CURSOS DE FORMACION TEORICA Y PRACTICA. MI ACTIVIDAD DOCENTE EN LA UNIVERSIDAD COMPLUTENSE COMIENZA EN MI ETAPA DE BECARIA PREDOCTORAL (2001) PARTICIPANDO EN LA DOCENCIA PRACTICA DE LAS ASIGNATURAS DE MICROBIOLOGIA E INMUNOLOGIA (ASIGNATURAS DE 2º CURSO DE LA LICENCIATURA DE VETERINARIA) QUE CONTINUA HASTA LA FECHA. ADEMAS HE IMPARTIDO CHARLAS EN CURSOS DE FORMACION DE LA COMUNIDAD DE MADRID,UNIVERSIDADES, ETC. HE DIRIGIDO TRABAJOS DE INVESTIGACION DE FIN DE GRADO Y DE MASTER Y HE SIDO TUTORA DE ALUMNOS DE CICLOS FORMATIVOS EN MI CENTRO DE TRABAJO (CENTRO DE VIGILANCIA SANITARIA VETERINARIA VISAVET).ACTUALMENTE DIRIJO UNA TESIS Y UNA TESINA ORIENTADAS A LA INVESTIGACION DE LA LEISHMANIOSIS EN RESERVORIOS ATIPICOS. DESDE EL AÑO 2016 ESTOY ACREDITADA PARA CONCURRIR AL CONCURSO DE ACCESO DE PROFESOR CONTRATADO DOCTOR DE LA UNIVERSIDAD